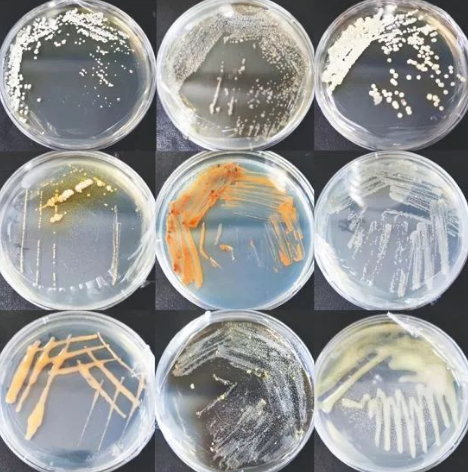
部分红树林放线菌形态图除了埋首科研,徐静研究团队成员还积极构建
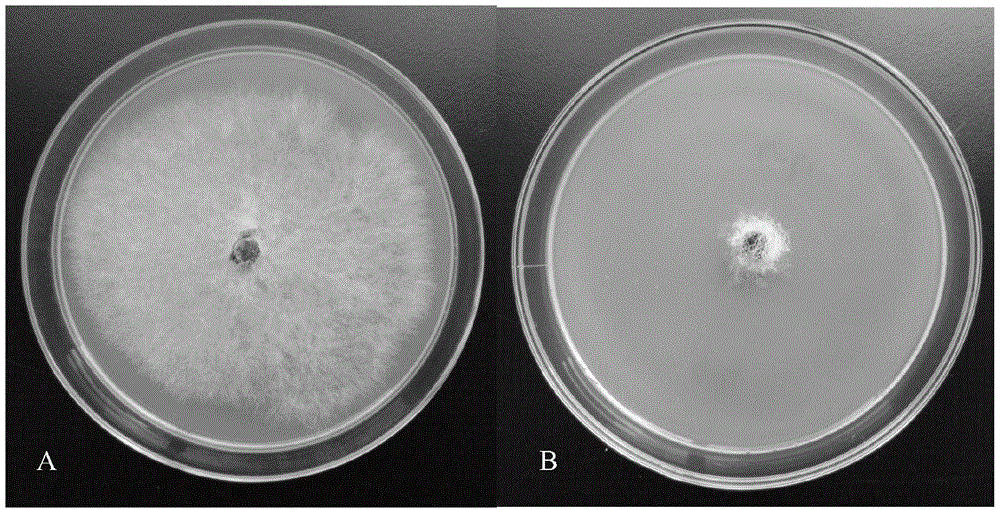
一株高效橡胶树根病生防拮抗放线菌及其应用

放线菌平板图片

橘色的放线菌菌落在琼脂平板上
图片尺寸1200x795
部分红树林放线菌形态图除了埋首科研,徐静研究团队成员还积极构建
图片尺寸468x472
土壤中放线菌的平板分离
图片尺寸180x178
具有广谱抗菌活性的放线菌及其应用的制作方法
图片尺寸977x1000
青藏高原阿里那曲和海西地区土壤可培养放线菌的多样性
图片尺寸548x242
放线菌培养09求助
图片尺寸1080x1440
放线菌图片
图片尺寸628x500
放线菌的形态
图片尺寸640x485
一种具有抗菌活性的放线菌及其应用的制作方法
图片尺寸1000x941
放线菌是什么?它的形态特征又是怎样的? - 知乎
图片尺寸601x444
放线菌的综述
图片尺寸771x535
放线菌阅读答案环境微生物之放线菌
图片尺寸587x326
摘要:在活化培养放线菌a45时,发现原平板上放线菌有被抑制现象,通过
图片尺寸1000x427
放线菌农用研究15放线菌自述
图片尺寸323x302
放线菌阅读答案环境微生物之放线菌
图片尺寸1029x1015
出土竹简饱水期间放线菌群落结构与功能
图片尺寸542x717
科普放线菌
图片尺寸500x375
放线菌
图片尺寸1080x810
放线菌阅读答案环境微生物之放线菌
图片尺寸462x602
一株高效橡胶树根病生防拮抗放线菌及其应用
图片尺寸1000x510